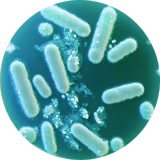

SOFT CHEWS
Natural Allergy Relief Chews







CLINICALLY PROVEN ALLERGY RELIEF
In a rigorous clinical trial, all participating dogs treated with our key ingredient L. sakei probio-65 experienced relief from skin problems. The study proved this powerful probiotic (originally from kimchi) delivers consistent results - reducing both scratching frequency and visible skin irritation in each test subject.

- Clinically Validated Ingredients
- 40+ Dog Testers
- Significant Improvements After 1 Month
- Proven in Placebo-Controlled Trials
Clinically Validated Ingredients
40+ Dog Testers
Significant Improvements After 1 Month
Proven in Placebo-Controlled Trials
57%
more improvement over the placebo in just 30 days*
*Based on clinical studies of individual ingredients, not the finished product.While studies suggest benefits, results may vary. This product is not intended to diagnose, treat, cure, or prevent any disease.
Powerful Ingredients, Proven by Science
Wolf Probiotic

Wolf Probiotic
This powerful probiotic blend from healthy wolves restores your dog's natural gut microbiome, boosting immunity and reducing allergic reactions—just as nature intended.
Salmon Oil

Salmon Oil
Rich in omega-3 fatty acids, this powerhouse ingredient supports your dog's immune system while helping to regulate histamine levels and soothe allergy-related inflammation.
Bovine Colostrum

Bovine Colostrum
Packed with immune-boosting nutrients, bovine colostrum helps balance histamine responses, supporting a strong defense against allergens and environmental irritants.
L. Sakei
L. Sakei
This beneficial postbiotic strengthens immunity and promotes a balanced gut microbiome, helping to reduce allergic reactions and improve overall well-being.
Natural Adjustment
Probiotics introduced; dog begins adjusting internally.
Gut Health Building
Beneficial gut bacteria start supporting immune response.
Visible Skin Improvements
Early skin improvements—less itching and irritation.
Clinically-proven relief
Less itching, redness, inflammation.
SIGNS YOUR DOG NEEDS ALLERGY CHEWS

Loved by pets, endorsed by vets
meet dr. Audrey Wystrach
“I’ve seen the best results with Stalmy Allergy Relief Chews. They contain a clinically-designed, proprietary mix of Wolf Probiotics that give your dog an Ancestral Advantage.”

Frequently ASked Questions
Why should my dog take Allergy Chews?
Why should my dog take Allergy Chews?
Does your dog suffer from any of these?
- Itching
- Scratching
- Paw licking
- Skin Biting
- Red, blotchy skin
- Hotspots on their fur
If so, these signs indicate that your dog may have allergies.
What are the ingredients in Allergy Chews?
What are the ingredients in Allergy Chews?
Driet bovine Colostrum
Astra Omega oil
Probrietary probiotic blend
Prebiotics & Post biotics
Does this have chicken in it?
Does this have chicken in it?
No. We know that some dogs have chicken allergies and made sure there is none in our product.
What is Ancestral Advantage?
What is Ancestral Advantage?
Ancestral Advantage is a way to help return your dog’s gut to that of their closest relatives - the wolf. In the process of domesticating dogs, we have completely changed their lifestyle. No longer do they roam the earth looking for food. They live in our houses, eating the same thing every day. Ancestral Advantage introduces a special blend of wolf probiotics that not only help diversify and strengthen your dog’s gut, it also enhances their immune system and helps maintain normal histamine levels.
Where are Allergy Chews made?
Where are Allergy Chews made?
Allergy Chews are formulated and manufactured here in the USA.
What's the dosage?
What's the dosage?
Allergy Chews can be given to your dog just like a treat! For dogs 50 pounds and under, 1 treat a day will do the trick. For dogs over 50 pounds, try 2 treats a day, and if you are still seeing signs of allergies, try giving them 3 treats a day.
Do dogs like the taste?
Do dogs like the taste?
We knew that there was no point in making something that fought allergies this well if you couldn’t get your dog to eat them. What’s the point? Dogs love the taste of Allergy Chews! Each treat is flavored with bone broth - and our dogs can’t get enough of them!
When will I receive my order?
When will I receive my order?
- For U.S residents, please allow 2-3 business days to process your order. We’ll send your tracking details the moment the order ships.
- You can expect to receive your package within 7 to 10 business days after your order has shipped, depending upon your location.
- Canadian customers: Your order may take up to 2 to 4 weeks to arrive, and may be split into multiple shipments to prevent any delays with customs due to quantity regulations.
Collapsible row
Collapsible row
Collapsible row
Collapsible row
How do I track my order?
How do I track my order?
You can track your order by chatting with us on our website or by emailing us at info@stalmy.com